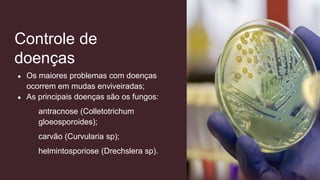
Controle de
doenças
● Os maiores problemas com doenças
ocorrem em mudas enviveiradas;
● As principais doenças são os fungos:
antracnose (Colletotrichum
gloeosporoides);
carvão (Curvularia sp);
helmintosporiose (Drechslera sp).

O açaí, cultivado principalmente na Amazônia, é uma importante fonte econômica para o Brasil, gerando cerca de 3 bilhões de reais anuais e 25 mil empregos diretos. O país é o maior exportador da polpa congelada, enquanto a produção se concentra principalmente no estado do Pará, com uma verticalização significativa na indústria de derivados. A cultura do açaí envolve práticas de plantio, colheita e beneficiamento que garantem a qualidade do produto final.